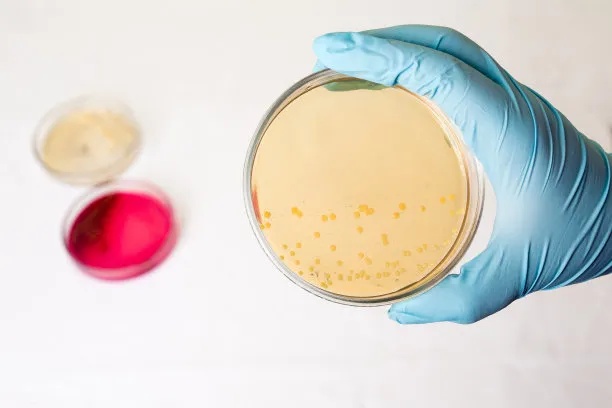

探索微生物世界:科研人员必备的菌种查询资源指南
这一庞大的资源网络不仅为科学研究提供了坚实基础,也为医药、农业、工业和环保等领域的持续创新注入了源源不断的活力。了解这些“隐形基石”的来源、识别方式、应用场景以及如何高效获取,已成为每一位科研工作者不可或缺的能力。
一、微生物菌种:生命科学的隐形基石
微生物菌种是指经过分离、纯化并稳定保存的特定微生物个体或群体,是开展生命科学研究的基本材料。它们广泛应用于基因工程、代谢产物开发、疾病模型构建、药物筛选等多个领域。例如,在疫苗研发中,减毒或灭活的病毒株是制备安全有效疫苗的前提;在合成生物学中,大肠埃希氏菌和酵母菌常被用作基因表达的“细胞工厂”,用于生产胰岛素、抗体药物及其他高附加值化合物。
此外,微生物还是天然活性物质的重要来源。许多抗生素、抗肿瘤药物和酶制剂均源自放线菌、真菌等微生物的次级代谢产物。随着对微生物多样性认知的不断深入,其在功能食品、益生菌产品、生物农药等方面的潜力也日益凸显。可以说,没有高质量、可追溯的菌种资源,现代生命科学的诸多突破将无从谈起。
正是由于其不可替代的基础性作用,全球各国纷纷建立和完善微生物保藏体系,以确保这些宝贵资源的安全保存与合法共享。接下来,我们将目光投向全球主要的菌种保藏中心,看看这张覆盖世界的资源版图是如何构成的。
二、全球菌种资源版图:从ATCC到中国保藏中心
在全球范围内,微生物菌种的保藏呈现出“多中心协同、专业化分工”的格局。国际上最具影响力的四大保藏中心包括美国典型培养物保藏中心(ATCC)、德国微生物与细胞培养物保藏中心(DSMZ)、荷兰韦斯特迪克真菌生物多样性研究院(CBS)和日本微生物菌种保藏中心(JCM),它们共同构成了全球微生物资源共享的核心枢纽。
美国典型培养物保藏中心(ATCC) 成立于1925年,是全球最早也是最知名的综合性生物资源中心之一。其保藏涵盖细菌、真菌、病毒、细胞系及质粒等多种生物材料,总数超过29,000种。ATCC提供的标准菌株被FDA、USP、EP、JP等国际药典广泛引用,是临床诊断、食品安全检测和科研实验中的“金标准”。
荷兰韦斯特迪克真菌生物多样性研究院(CBS) 是世界上规模最大的专业真菌保藏机构,保藏活体真菌菌株超过10万株,涵盖80%以上的已知真菌属。其馆藏不仅包括酵母、霉菌和大型食用菌,还包括植物病原菌、极端环境真菌和药用功能菌株,是真菌分类学、生态学和应用研究的重要基地。
日本微生物菌种保藏中心(JCM) 隶属理化学研究所Riken生物资源中心,成立于1981年,保藏微生物材料逾20,000种。JCM的一大特色是建有日本专利微生物库,保管着3,000多株与专利程序相关的菌种,并专注于深海、火山等极端环境微生物的收集与研究。
在中国,已建立起覆盖医学、农业、工业、海洋等多领域的国家级菌种保藏网络。主要机构包括:
• 中国普通微生物菌种保藏管理中心(CGMCC):依托中科院微生物研究所,保藏各类微生物超11.5万株,承担国家专利程序生物材料保藏任务,是《布达佩斯条约》指定的国际保藏单位(IDA)之一。
• 中国药学微生物菌种保藏管理中心(CPCC):以放线菌和真菌为特色,保藏具抗肿瘤、抗耐药菌活性的药学微生物62,038余株,资源来自极地、深海等特殊生境。
• 中国工业微生物菌种保藏管理中心(CICC):服务于食品、药品、化妆品等行业,保藏益生菌、标准菌株及芽胞悬液等1.4万余株。
• 中国海洋微生物菌种保藏管理中心(MCCC):拥有全球最大海洋微生物菌种库,保藏来自三大洋及南北极的菌种3.2万株,含嗜盐、嗜冷等功能菌群。
这一体系的建成,使我国在全球微生物资源竞争中占据了有利位置。然而,仅有资源还不够,如何准确识别这些千差万别的微生物,是实现精准应用的关键一步。

金黄色葡萄球菌革兰氏染色显微图像(紫红色葡萄串状排列)
三、鉴定技术革新:如何精准识别微生物世界
传统的微生物鉴定依赖形态观察、生理生化试验等方法,耗时长且分辨率有限,难以应对复杂样本或近缘物种的区分。随着分子生物学的发展,现代鉴定技术正朝着快速化、智能化和高精度方向演进。
16S rRNA测序 已成为细菌分类与系统发育分析的“金标准”。通过扩增并比对16S rRNA基因序列,可在数小时内完成对未知菌株的初步鉴定,广泛应用于环境微生物群落分析和新种发现。
MALDI-TOF MS(基质辅助激光解吸飞行时间质谱)则实现了蛋白质指纹图谱的快速识别。该技术能在数分钟内完成对临床病原菌的鉴定,灵敏度高、重复性好,已在医院微生物实验室广泛应用,显著提升了感染性疾病的诊疗效率。
更进一步的是全基因组测序(WGS)。通过对整个基因组进行测序与比对,不仅能实现种水平甚至株水平的精确溯源,还可同步分析耐药基因、毒力因子和代谢通路,为流行病学调查、合成生物学改造提供全面数据支持。
新兴技术也在不断涌现。例如,AI赋能拉曼光谱可在单细胞水平实现秒级鉴定,并预测最小抑菌浓度(MIC);纳米孔宏基因组测序(mNGS)无需培养即可直接检测样本中的所有微生物,将重症感染的病原检测周期从传统方法的5–7天缩短至6–8小时。
值得一提的是,《中国药典》2025年版新增了《微生物MALDI-TOF MS鉴定技术指导原则》和《全基因组测序技术指导原则(9110)》,标志着我国已建立起系统化、多维度的微生物鉴定与溯源技术标准体系。这些技术进步不仅加快了科研进程,也为产业应用提供了可靠保障。
了解了菌种的来源与识别方法后,我们再来看看它们在实际场景中是如何发挥巨大价值的。
四、应用实例:菌种如何推动医药、食品与环保发展
医药领域:从基因工程到活体治疗
在医药研发中,微生物既是工具,也是疗法本身。大肠埃希氏菌作为经典的基因工程宿主,已被用于大规模生产胰岛素、人生长激素和多种重组蛋白药物。近年来,工程化细菌更被设计为“活体药物”用于癌症治疗。例如,经基因改造的沙门氏菌saltikva携带IL-2基因,可在肿瘤微环境中激活免疫系统,二期临床试验显示其联合化疗可显著延长转移性胰腺癌患者的生存期。
另一项突破性应用是粪菌移植(FMT)。研究表明,在非小细胞肺癌(NSCLC)患者中,FMT联合抗PD-1治疗的客观缓解率(ORR)高达80%(16/20),显示出调节肠道微生态对抗肿瘤的巨大潜力。
食品安全:保鲜、发酵与脱毒
在食品工业中,微生物技术贯穿于生产、保鲜与安全保障全过程。枯草芽孢杆菌作为一种拮抗菌,当以10⁸ CFU/mL浓度施用于油桃表面时,可完全抑制褐腐病的发生。乳酸链球菌产生的Nisin是一种天然防腐剂,已被50多个国家批准使用,我国年产量已超25吨。
在脱毒方面,改性酵母细胞壁对黄曲霉毒素B1的吸附容量较天然酵母提升5.7倍,而某些乳酸菌还能有效降解呕吐毒素(DON),为饲料安全提供解决方案。
环境保护:污染治理与生态修复
微生物被誉为“绿色工程师”,在环境修复中展现出卓越效能。中国科学院团队通过合成生物学构建的工程菌VCOD-15,可在盐度高达102.5 g/L的氯碱废水中,48小时内将联苯、苯酚、萘等五种芳香污染物去除率均提升至60%以上。
在农业生态修复中,南京工业大学团队构建的复合菌群在内蒙古盐碱地试验中使小麦增产35%,同时土壤钠吸附比(SAR)降低28%。漳州采用“菌藻协同”模式处理畜禽养殖沼液,3天内氨氮浓度从300–500 ppm降至0.17 ppm,COD去除率达93.1%。
这些案例充分证明,微生物不仅是自然界的分解者,更是解决人类面临的健康、粮食与环境挑战的潜在“特种兵”。

科研人员在生物安全柜中进行微生物接种操作实景图
五、高效查询平台:助力科研人员的实用工具
面对如此庞大而分散的全球菌种资源,如何快速、准确地找到所需菌株?传统的信息检索方式往往效率低下,且存在数据更新滞后、渠道不透明等问题。为此,一批专业的在线查询与服务平台应运而生,成为连接科研需求与实体资源的桥梁。
其中,由北京百欧博伟生物技术有限公司建设维护的微生物菌种查询网(www.biobw.org),凭借其资源整合能力与服务响应速度,逐渐成为科研人员常用的工具之一。该平台整合国内外菌种资源超过12万株,其中国内保藏7万余株,国外引进4万余株,基本覆盖常见研究需求。网站还收录细胞系超1万株,提供5000余套培养基配方及400余种质粒载体信息,部分资源免费开放,极大便利了实验方案的设计与优化。
平台的一大优势在于其持续更新机制与便捷的检索功能。用户可通过菌种名称、分类地位、功能特性等多维度进行筛选,并获取详细的保藏信息、培养条件与应用背景。作为美国ATCC、德国DSMZ、荷兰CBS、日本JCM等国际知名保藏中心的代理单位,该平台支持进口菌种的短周期交付服务,满足GLP/GMP合规要求。
此外,平台配备Biolog微生物鉴定系统、超低温存储设备等专业技术设施,可提供定量菌悬液定制、菌种鉴定与保藏等延伸服务。目前,该平台已服务于中国医学科学院、北京大学、深圳市易瑞生物、广东省妇幼保健院等众多科研机构与企业单位,形成了稳定的行业合作网络。
恒温培养箱内培养皿菌落生长情况特写
从生命科学的隐形基石,到遍布全球的保藏网络;从精准识别的技术飞跃,到医药、食品与环保领域的广泛应用,微生物菌种的价值正在被不断挖掘。而像微生物菌种查询网这样的高效工具,则为科研人员打通了从“想法”到“实验”的最后一公里。未来,随着资源积累的深化与技术手段的升级,这个微观世界将继续为人类社会的可持续发展贡献不可估量的力量。
免责声明:此文内容为广告或转载宣传资讯,相关素材由广告主提供,与本网无关。仅供读者参考并请自行核实相关内容。
【免责声明】
(此文为在诸城新闻网出于传播更多信息的转载发布,不代表本网的观点及立场。所涉文、图等资料的一切权力和法律责任归材料提供方所有和承担。文章内容仅供参考,不构成任何购买、投资等建议,据此操作风险自担!)
